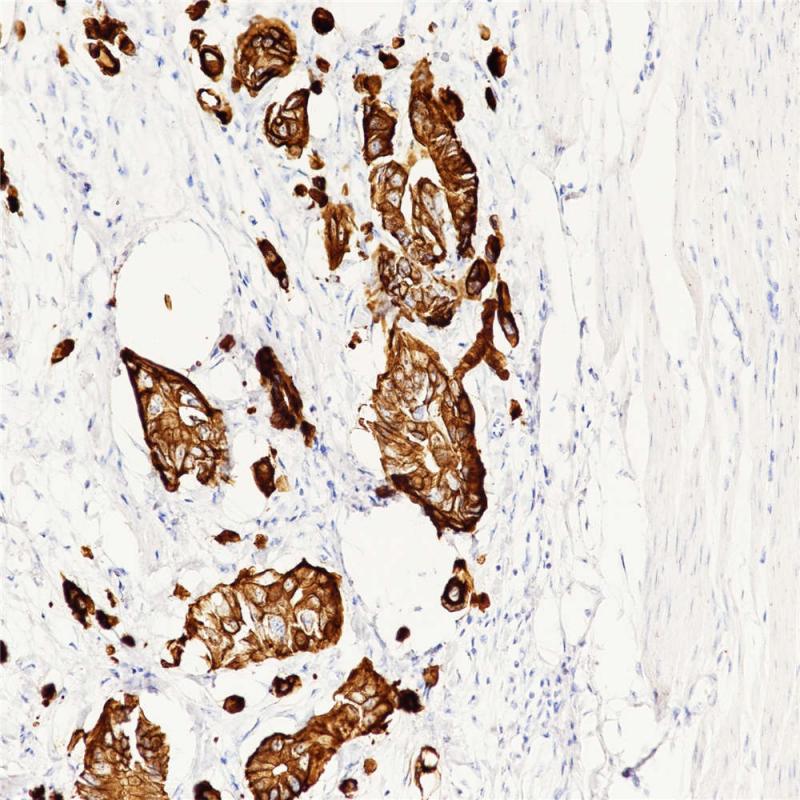
结肠腺癌 CK20 (BP6030) 染色

产品中心
结肠腺癌 CK20 (BP6030) 染色

结肠 CK20 (BP6030) 染色
Cytokeratin 20 重组兔单克隆抗体
CK20是一种具有限制表达模式的单层上皮角蛋白,其II型配对通常为CK8。CK20在正常组织表达于胃小凹上皮、大小结肠上皮、膀胱上皮、一些神经内分泌细胞以及Merkel细胞。肿瘤组织中,CK20表达于结肠腺癌,胃腺癌,胰腺癌,胆管癌,卵巢粘液腺癌,尿路上皮癌以及Merkel细胞癌。CK20通常与CK7及其他抗体联合表达,用于区分结肠癌(CK20+)和卵巢癌,肺癌及乳腺癌。
Specifications
- 目录号
- BX50025
- 克隆号
- BP6030
- 阳性对照
- 结肠腺癌
- 亚细胞定位
- 细胞质
- 组织类型
- FFPE
- 修复方式
- HIER
- 稀释比
- 1:100-1:200
- 规格
- 100μl/vial, 1ml/vial
- 用途
- RUO
Reference
1.Scott MP, et.al, Am J Dermatopathol. 1999. Feb;21(1):16-20.
2.Moll R, et.al, Am J Pathol. 1992 Feb;140(2):427-47.


